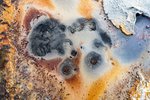
Heima er bezt

Mest lesið undanfarið ár
-
1Fréttir6Sökuð um að hrella minnst níu einstaklinga: „Hann er minn !“
Níu einstaklingar telja sig hafa orðið fyrir barðinu á sama eltihrellinum, 37 ára gamalli konu sem er búsett í Reykjanesbæ. -
2Fréttir6Sjónarvitni sáu dóttur beita aldraða foreldra miklu ofbeldi
Tvö sjónarvitni sem Heimildin ræddi við sáu konu beita báða foreldra sína ofbeldi áður en hún var handtekin vegna gruns um að hafa banað föður sínum. Konan, sem er 28 ára gömul, situr nú í gæsluvarðhaldi eftir að faðir hennar fannst látinn á heimili fjölskyldunnar á Arnarnesinu í Garðabæ. -
3English1Climeworks’ capture fails to cover its own emissions
The carbon capture company Climeworks only captures a fraction of the CO2 it promises its machines can capture. The company is failing to carbon offset the emissions resulting from its operations – which have grown rapidly in recent years. -
4FréttirHátekjulistinnSkattakóngur á 42 ára gömlum Benz: Velgengnin kostaði hjónabandið
Sigurður Elías Guðmundsson, sem er tekjuhæstur á Suðurlandi, minnir á að mikill tími fari í farsæla uppbyggingu á rekstri og því fylgi miklar fórnir einnig. Þannig hafi reksturinn kostað hann hjónabandið. -
5ViðtalVöknuðu upp við martröð
„Það er búið að taka frá honum öryggi og traust,“ segir móðir tíu ára drengs sem lýsti alvarlegum atvikum þegar maður braust inn á heimili fjölskyldunnar í Hafnarfirði. Foreldrar drengsins segja frá átakanlegri nótt sem hefur markað líf þeirra síðan, í von um að saga þeirra hjálpi öðrum sem upplifa alvarleg áföll. -
6GreiningHátekjulistinn4Hátekjulistinn sýnir okkur virði kvótans
Baráttan á Alþingi um veiðigjöldin varð til þess að tekjur ríkisins hækka um nokkra milljarða á ári. Útgerðarkóngar toppa Hátekjulistann um land allt, sumir með milljarða í tekjur hver. Sex fjölskyldur eiga um helming kvótans og gróðinn streymir í óskyldar greinar og til næstu kynslóða. -
7Pistill1Sif Sigmarsdóttir
Óskemmtileg upplifun við Leifsstöð
Skyndilega kom maður aðvífandi. Ógnandi í fasi hóf hann að berja í bílinn af afli. -
8ViðtalGrunnstoðir heilsu3Breytt fæði breytti líðaninni
Kristjana Pálsdóttir og Sigurður Pétur Harðarson ákváðu í vetur að gera breytingar á mataræði sínu en þau áttu bæði við kvilla að stríða eins og háan blóðþrýsting, svefnvanda, voru of þung og fleira mætti telja. Árangurinn hefur ekki látið á sér standa. -
9InnlentÞrjár konur kvartað undan áreitni starfsmanns RÚV
Stjórnendum hjá Ríkisútvarpinu hafa borist kvartanir frá þremur konum vegna áreitni af hálfu karlkyns starfsmanns fjölmiðilsins. Maðurinn er í leyfi frá störfum. Fyrstu kvartanirnar bárust í ágúst. -
10Viðskipti2Fjárfesti í íslenskum félögum eftir að Ásgeir varð seðlabankastjóri
Sjóður Helgu Viðarsdóttur, unnustu Ásgeirs Jónssonar seðlabankastjóra, tók þátt í frumútboði Íslandsbanka árið 2021. Seðlabankinn sagði gengi krónu og vaxtaákvarðanir ekki hafa áhrif á sjóðinn, enda fjárfestingar sjóðsins erlendis. Veik króna gagnvart dollara kom „eins og bónus“ sagði Helga.